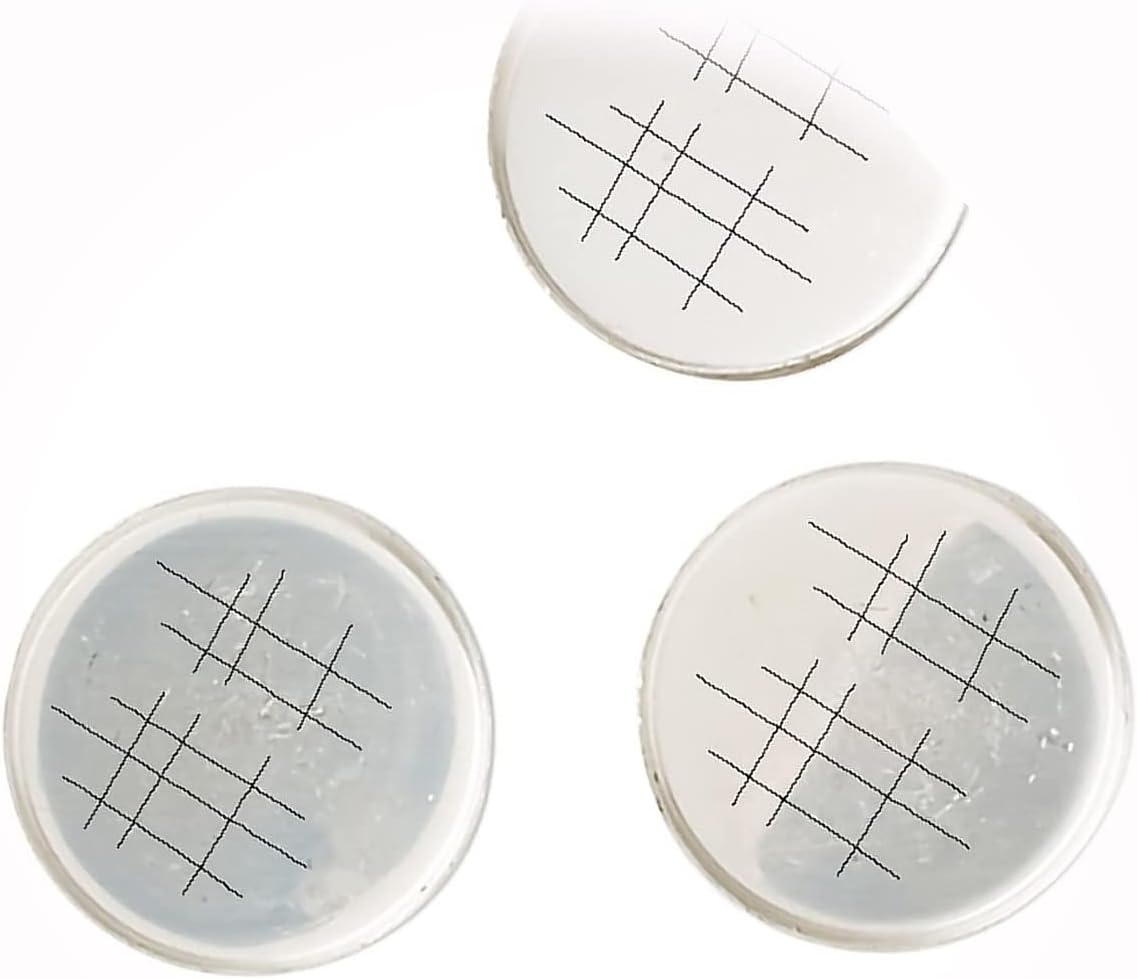

Home
/
Jewelry
Jewelry
Clear all
New 1000 Gold Plated Brass Smooth 4mm Round Beads with 0.8mm Hole for DIY Crafts and Jewelry Making LU06481MAR
$ 99.70
$ 341.98
Save
$ 242.28
New 50 Grams (60-70) Shiny 100% Copper Beads & Bead Cap Design Mix for DIY Crafts and Jewelry Making LU06063MAR
$ 73.99
$ 147.98
Save
$ 73.99
New 100 Shiny Gold Plated Brass 25x6mm Single Sided Feather Focal Charms for DIY Crafts and Jewelry Making LU06036MAR
$ 68.99
$ 137.98
Save
$ 68.99
New 1 Strand (30) Gorgeous Copper 14mm Round Shell Pearl Beads for DIY Crafts and Jewelry Making LU06192MAR
$ 85.99
$ 171.98
Save
$ 85.99
New 4 Gold Plated Copper Red & Green 16mm Round Beads with Cut Outs for DIY Crafts and Jewelry Making LU06196MAR
$ 85.99
$ 171.98
Save
$ 85.99
New Ten Strands Cultured Freshwater 4-10mm Mixed Shapes Pearls for DIY Crafts and Jewelry Making LU06413MAR
$ 99.09
$ 253.98
Save
$ 154.89
New 4 Sterling Silver 12mm Round Unpolished Bezel Solid Back Setting Cup for DIY Crafts and Jewelry Making LU05965MAR
$ 64.99
$ 129.98
Save
$ 64.99